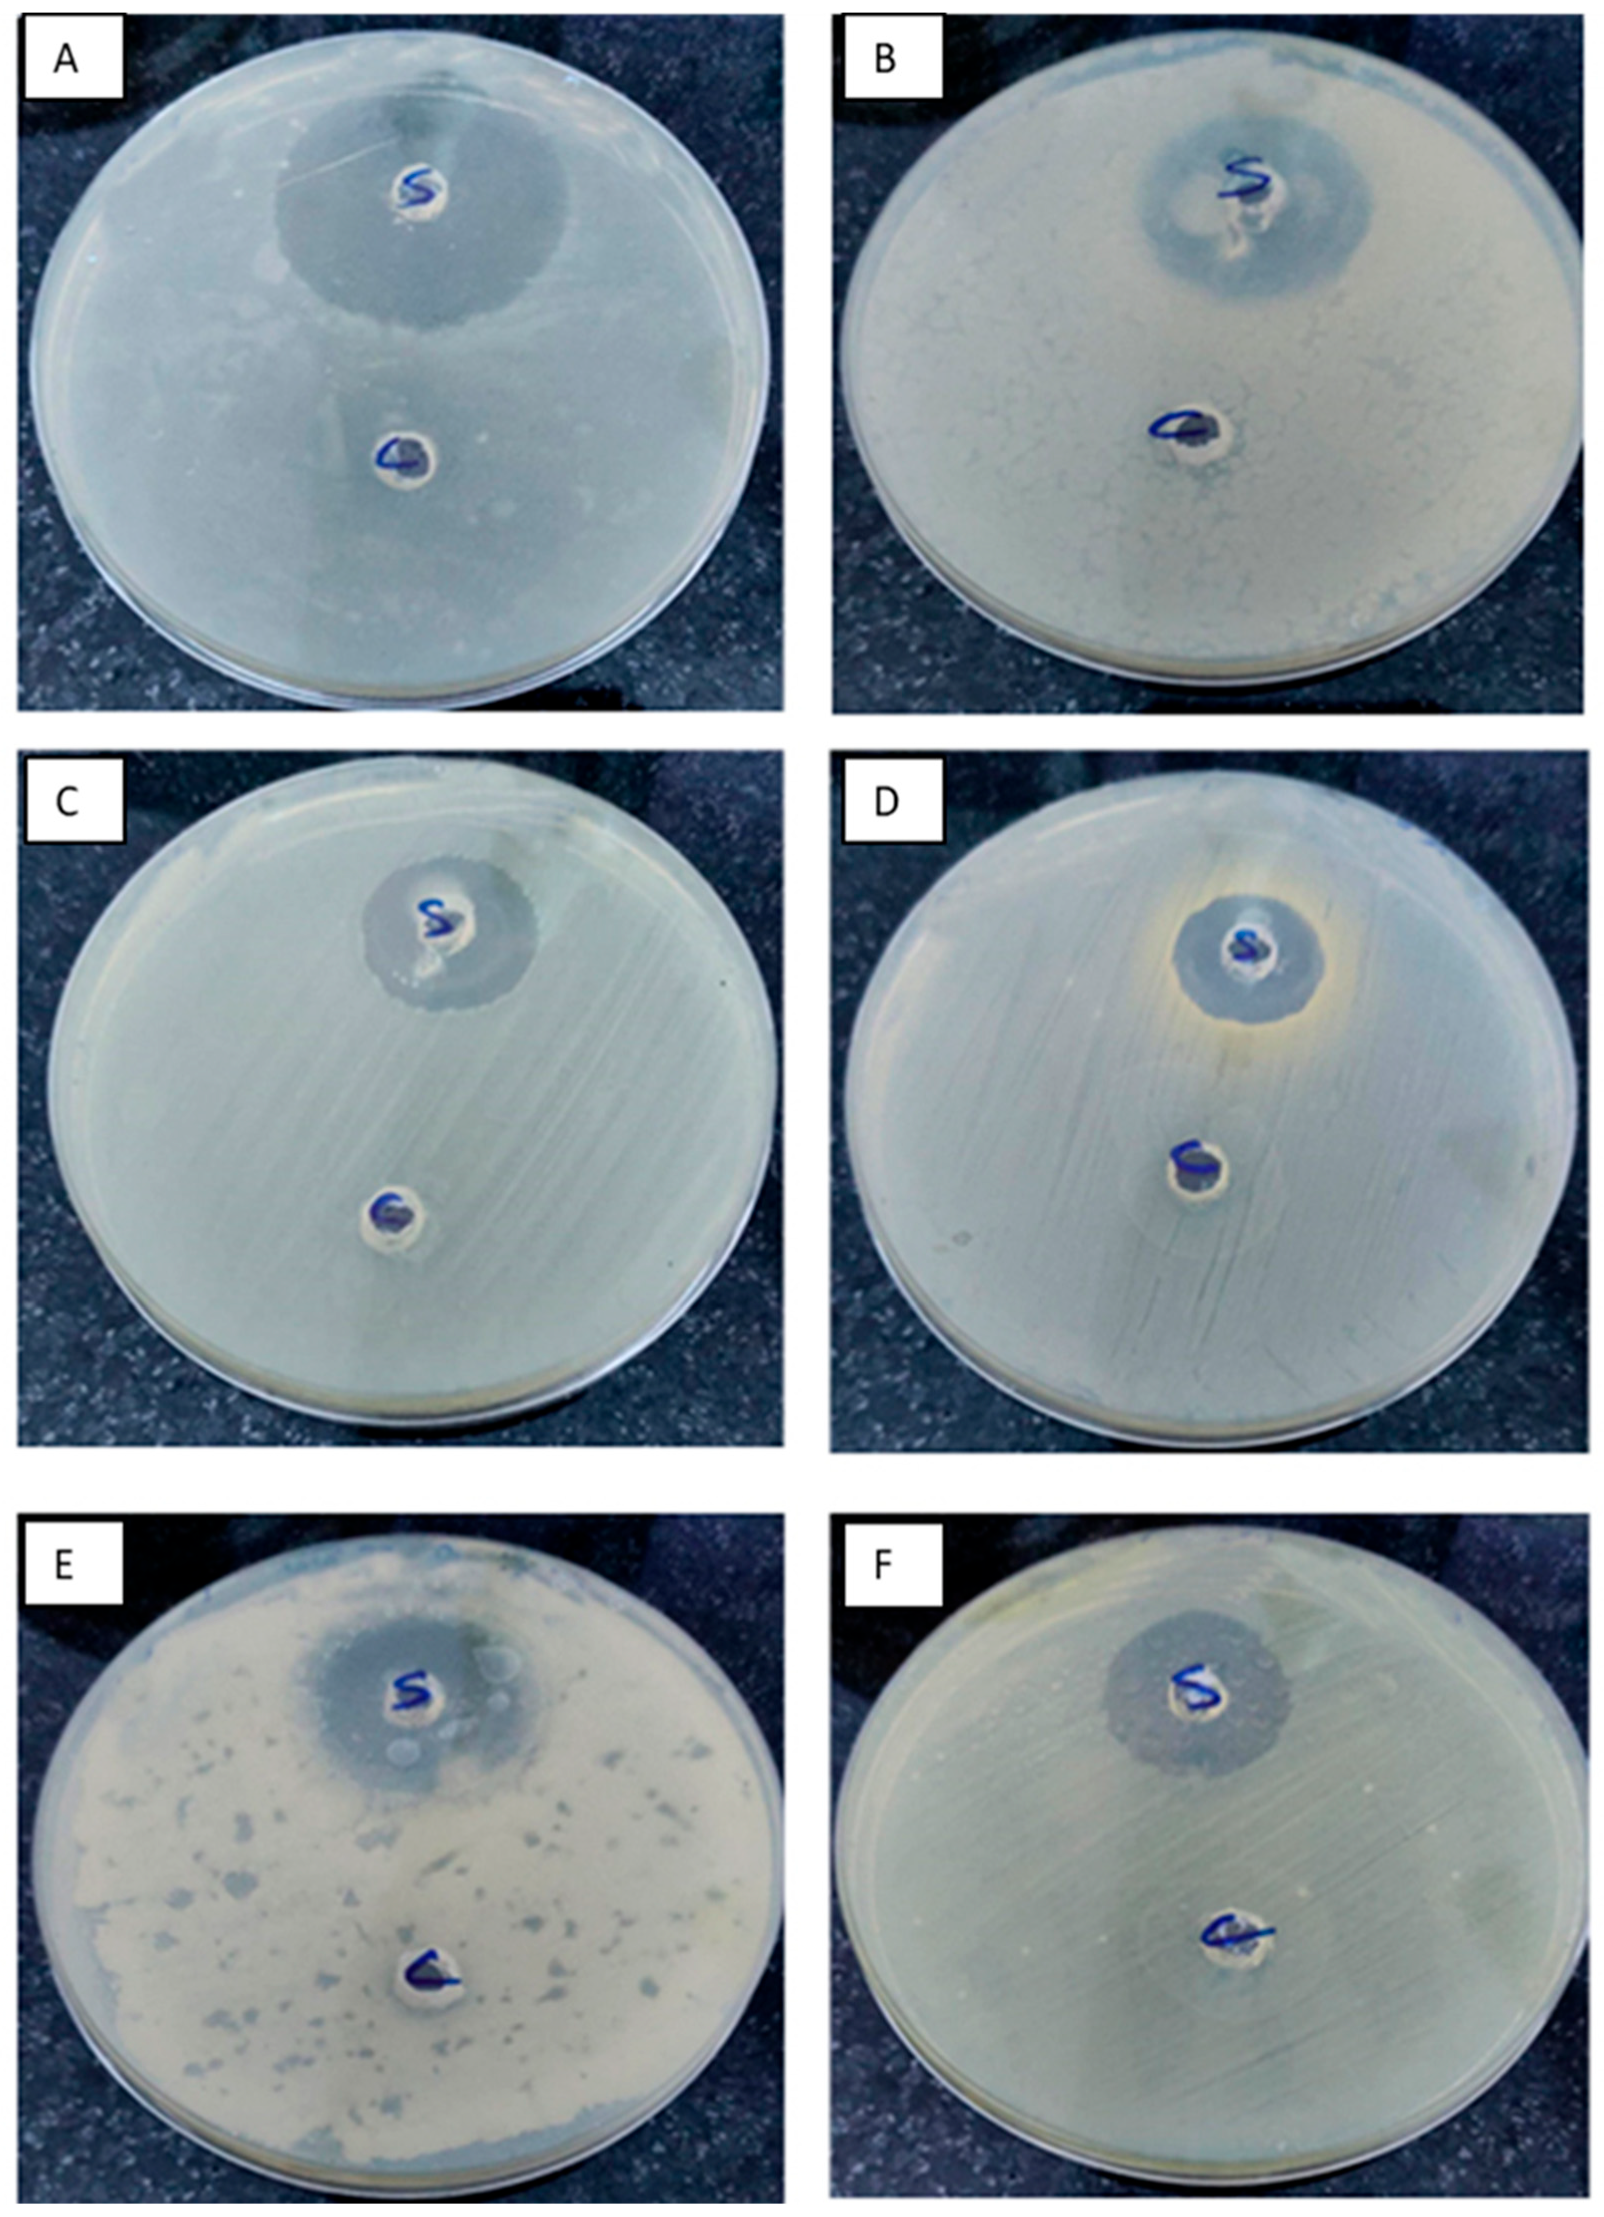
Agronomy 12 02818 g011

Antioxidants, Antimicrobial, and Anticancer Activities of Purified Chitinase of Talaromyces funiculosus Strain CBS 129594 Biosynthesized Using Crustacean Bio-Wastes
Abstract
1. Introduction
2. Materials and Methods
2.1. Microorganisms
2.2. Preparation of the Crustacean Shell Powder and Colloidal Chitin
2.3. Genetic Identification of the Fungus
2.4. Chitinase Production through Solid State Fermentation (SSF) and Extraction
2.5. Determination of Chitinase and Protein
2.6. Effect of Additives and Agro-Industrial on Chitinase Production
2.7. Effect of Different Incubation Period, Inoculum Size, and NaCl on Chitinase Production
2.8. Purification of Chitinase Enzyme
2.9. Molecular Weight Determination
2.10. Amino Acid Analysis
2.11. Temperature, pH Optima, and Stability
2.12. Effect of Metal Ions on the Purified Chitinase
2.13. Biological Activities of the Crude Enzyme
2.13.1. Free Radical Scavenging Activity
2.13.2. ABTS Radical Cation Decolorization Assay
2.13.3. Antimicrobial Activity of Pure Chitinase
2.14. Anticancer Activity
Determination of Sample Cytotoxicity on Cells (MTT Protocol)
2.15. Statistical Analysis
3. Results
3.1. Screening for Chitinase Production by Some Fungi
3.2. Molecular Identification of the Fungus Producing the Most Chitinase
3.3. Effect of Moisture Content (MC) and Shellfish Waste as a Substrate Medium Ratio on the Production of Chitinase on SSF Technique
3.4. Effect of Weight of Crab Shellfish Waste on Chitinase Production
3.5. Optimization of Chitinase Production
3.6. Chitinase Purification
3.7. Sodium Dodecyl Sulfate-Polyacrylamide Gel Electrophoresis (SDS-PAGE)
3.8. Amino Acid of Purified Chitinase
3.9. Effect of Temperature and Thermal Stability on the Activity of Purified Chitinase
3.10. Effect of pH on the Activity of Purified Chitinase
3.11. Effect of Metal Ions and Inhibitors on Purified Chitinase Activity
3.12. Antioxidant Activity of Purified Chitinase
3.13. Antimicrobial Activity of Purified Chitinase
3.14. Anticancer Activity of Purified Chitinase
4. Discussion
5. Conclusions
Author Contributions
Funding
Institutional Review Board Statement
Informed Consent Statement
Data Availability Statement
Acknowledgments
Conflicts of Interest
References
- Basurco, B.; Zaragoza, C.M.; Carballo, J.; Lem, A. Seafood in Mediterranean countries. In International Centre for Advanced Mediterranean Agronomic Studies (CIHEAM), CIHEAM—MEDITERRA 2014 Logistics and Agro-Food Trade. A Challenge for the Mediterranean; Presses de Sciences Po: Paris, France, 2014; pp. 173–202. [Google Scholar]
- Arbia, W.; Arbia, L.; Adour, L.; Amrane, A. Chitin extraction from crustacean shells using biological methods—A review. Food Technol. Biotechnol. 2013, 51, 12–25. [Google Scholar]
- FAO. The State of Fisheries and Aquaculture; Food and Agriculture Organization of the United Nations: Rome, Italy, 2014. [Google Scholar]
- Kandra, P.; Challa, M.M.; Padma, J.H.K. Efficient use of shrimp waste: Present and future trends. Appl. Microbiol. Biotechnol. 2012, 93, 17–29. [Google Scholar] [CrossRef] [PubMed]
- Handayani, A.D.; Indraswati, N.; Ismadji, S. Extraction of astaxanthin from giant tiger (Panaeus monodon) shrimp waste using palm oil: Studies of extraction kinetics and thermodynamic. Bioresource Technol. 2008, 99, 4414–4419. [Google Scholar] [CrossRef] [PubMed]
- Santos, V.P.; Marques, N.S.S.; Maia, P.C.S.V.; Lima, M.A.B.; Franco, L.O. Seafood waste as attractive source of chitin and chitosan production and their applications. Inter. J. Mol. Sci. 2020, 21, 4290. [Google Scholar] [CrossRef] [PubMed]
- Lopes, C.; Antelo, L.T.; Franco-Uría, A.; Alonso, A.A.; Pérez-Martín, R. Chitin production from crustacean biomass: Sustainability assessment of chemical and enzymatic processes. J. Cleaner Product. 2018, 172, 4140–4151. [Google Scholar] [CrossRef]
- Batista, A.C.L.; Souza Neto, F.E.; Paiva, W.S. Review of fungal chitosan: Past, present and perspectives in Brazil. Polímeros 2018, 28, 275–283. [Google Scholar] [CrossRef]
- Elsoud, M.M.A.; El Kady, E.M. Current trends in fungal biosynthesis of chitin and chitosan. Bull. Natl. Res. Cent. 2019, 43, 59. [Google Scholar] [CrossRef]
- Rajput, M.; Kumar, M.; Pareek, N. Myco-chitinases as versatile biocatalysts for translation of coastal residual resources to eco-competent chito-bioactives. Fungal. Biol. Rev. 2022, 41, 52–69. [Google Scholar] [CrossRef]
- Lodhi, G.; Kim, Y.S.; Hwang, J.W.; Kim, S.K.; Jeon, Y.D.; Je, J.Y.; Ahn, B.B.; Moon, S.H.; Jeon, B.T.; Park, P.J. Chitooligosaccharide and its derivatives: Preparation and biological applications. Biomed. Res. Int. 2014, 2014, 654913. [Google Scholar] [CrossRef]
- Patel, S.; Goyal, A. Chitin and chitinase: Role in pathogenicity, allergenicity and health. Int. J. Biol. Macromol. 2017, 97, 331–338. [Google Scholar] [CrossRef]
- Kumar, A.; Kumar, D.; George, N.; Sharma, P.; Gupta, N. A process for complete biodegradation of shrimp waste by a novel marine isolate Paenibacillus sp. AD with simultaneous production of Chitinase and chitin oligosaccharides. Int. J. Biol. Macromol. 2018, 109, 263–272. [Google Scholar] [CrossRef]
- Akeed, Y.; Atrash, F.; Naffaa, W. Partial purification and characterization of chitinase produced by Bacillus licheniformis B307. Heliyon 2020, 6, e03858. [Google Scholar] [CrossRef]
- Berini, F.; Presti, I.; Beltrametti, F.; Pedroli, M.; Varum, K.M.; Pellegioni, L.; Sjöling, S.; Marinelli, F. Production and characterization of a novel antifungal chitinase identified by functional screening of a suppressive-soil metagenome. Microb. Cell Fact. 2017, 16, 16. [Google Scholar] [CrossRef]
- Hamid, R.; Khan, M.A.; Ahmad, M.; Ahmad, M.M.; Abdin, M.Z.; Musarrat, J.; Javed, S. Chitinases: An update. J. Pharm. BioAllied. Sci. 2013, 5, 21. [Google Scholar] [CrossRef]
- Singh, V.; Haque, S.; Niwas, R.; Srivastava, A.; Pasupuleti, M.; Tripathi, C.K.M. Strategies for fermentation medium optimization: An in-depth review. Front. Microbiol. 2017, 7, 2087. [Google Scholar] [CrossRef]
- Sukalkar, S.R.; Kadam, T.A.; Bhosale, H.J. Optimization of chitinase production from Streptomyces macrosporeus m1. Res. J. Life Sci. Bioinf. Pharmaceut. Chem. Sci. 2018, 4, 106–114. [Google Scholar]
- Alves, T.B.; Ornela, O.P.H.; de Oliveira, A.H.C.; Jorge, J.A.; Guimarães, L.H.S. Production and characterization of a thermostable antifungal chitinase secreted by the filamentous fungus Aspergillus niveus under submerged fermentation. 3 Biotech 2018, 8, 369. [Google Scholar] [CrossRef]
- Spadaro, D.; Droby, S. Development of biocontrol products for postharvest diseases of fruit: The importance of elucidating the mechanisms of action of yeast antagonists. Trends Food Sci. Technol. 2016, 47, 39–49. [Google Scholar] [CrossRef]
- Di Francesco, A.; Martini, C.; Mari, M. Biological control of postharvest diseases by microbial antagonists: How many mechanisms of action? Eur. J. Plant Pathol. 2016, 145, 711–717. [Google Scholar] [CrossRef]
- Busby, J.N.; Landsberg, M.J.; Simpson, R.M.; Jones, S.A.; Hankamer, B.; Hurst, M.R.H.; Lott, J.S. Structural analysis of Chi1 chitinase from Yen-Tc: The multisubunit insecticidal ABC toxin complex of Yersinia entomophaga. J. Mol. Biol. 2012, 415, 359–371. [Google Scholar] [CrossRef]
- Hamed, M.M.; Abd El-Mobdy, M.A.; Kamel, M.T.; Mohamed, H.I.; Bayoumi, A.E. Phytochemical and biological activities of two asteraceae plants Senecio vulgaris and Pluchea dioscoridis L. Pharmacol. Online 2019, 2, 101–121. [Google Scholar]
- Senapati, S.; Mahanta, A.K.; Kumar, S.; Maiti, P. Controlled drug delivery vehicles for cancer treatment and their performance. Signal Transduct. Target Ther. 2018, 3, 7. [Google Scholar] [CrossRef] [PubMed]
- Riganti, C.; Mini, E.; Nobili, S. Multidrug resistance in cancer: Pharmacological strategies from basic research to clinical issues. Front. Oncol. 2015, 5, 105. [Google Scholar] [CrossRef] [PubMed]
- El-Beltagi, H.S.; Mohamed, H.I.; Abdelazeem, A.S.; Youssef, R.; Safwat, G. GC-MS analysis, antioxidant, antimicrobial and anticancer activities of extracts from Ficus sycomorus fruits and leaves. Not. Bot. Horti. Agrobot. Cluj-Napoca 2019, 47, 493–505. [Google Scholar] [CrossRef]
- El-Beltagi, H.S.; Dawi, F.; Ashoush, I.S.; Ramadan, K.M.A. Antioxidant, anticancer and ameliorative activities of Spirulina platensis and pomegranate juice against hepatic damage induced by CCl4. Not. Bot. Hort. Agrobot. Cluj-Napoca 2020, 48, 1941–1956. [Google Scholar] [CrossRef]
- El-Beltagi, H.S.; Dawi, F.; Aly, A.A.; El-Ansary, A.E. Chemical compositions and biological activities of the essential oils from gamma irradiated celery (Apium graveolens L.) seeds. Not. Bot. Hort. Agrobot. Cluj-Napoca 2020, 48, 2114–2133. [Google Scholar] [CrossRef]
- Rajendrasozhan, S.; Moll, H.E.; Snoussi, M.; Romeilah, R.M.; El-Beltagi, H.S.; Shalaby, E.A.; Younes, K.M.; El-Beltagi, H.S. Phytochemical screening and antimicrobial activity of various extracts of aerial parts of Rhanterium epapposum. Processes 2021, 9, 1351. [Google Scholar] [CrossRef]
- Abdel-Rahim, E.A.; El-Beltagi, H.S. Constituents of apple, parsley and lentil edible plants and their therapy treatments for blood picture as well as liver and kidney functions against lipidemic disease. Elec. J. Environ. Agricult. Food Chem. 2010, 9, 1117–1127. [Google Scholar]
- Shallan, M.A.; El-Beltagi, H.S.; Mona, A.M.; Amera, T.M.; Sohir, N.A. Effect of amylose content and pre-germinated brown rice on serum blood glucose and lipids in experimental animal. Aust. J. Basic Appl. Sci. 2010, 4, 114–121. [Google Scholar]
- Romeilah, R.M.; El-Beltagi, H.S.; Shalaby, E.A.; Younes, K.M.; El Moll, H.; Rajendrasozhan, S.; Mohamed, H.I. Antioxidant and cytotoxic activities of Artemisia monosperma L. and Tamarix aphylla essential oils. Not. Bot. Horti Agrobot. Cluj-Napoca 2021, 9, 12233. [Google Scholar] [CrossRef]
- Valko, M.; Leibfritz, D.; Moncol, J.; Cronin, M.T.; Mazur, M.; Telser, J. Free radicals and antioxidants in normal physiological functions and human disease. Int. J. Biochem. Cell Biol. 2007, 39, 44–84. [Google Scholar] [CrossRef]
- Sofy, M.R.; Mohamed, H.I.; Dawood, M.F.A.; Abu-Elsaoud, A.M.; Soliman, M.H. Integrated usage of Trichoderma harzianum and biochar to ameliorate salt stress on spinach plants. Arch. Agr. Soil Sci. 2021, 68, 2005–2026. [Google Scholar] [CrossRef]
- El-Beltagi, H.S.; Mohamed, H.I.; Aldaej, M.I.; Al-Khayri, J.M.; Rezk, A.A.; Al-Mssallem, M.Q.; Sattar, M.N.; Ramadan, K.M.A. Production and antioxidant activity of secondary metabolites in Hassawi rice (Oryza sativa L.) cell suspension under salicylic acid, yeast extract, and pectin elicitation. Vitr. Cell Dev. Biol. Plant 2022, 58, 615–629. [Google Scholar] [CrossRef]
- El-Beltagi, H.S.; Eshak, N.S.; Mohamed, H.I.; Bendary, E.S.A.; Danial, A.W. Physical characteristics, minerals content, antioxidants and antibacterial activities of Punica granatum or Citrus sinensis peel extracts and their applications to improve cake quality. Plants 2022, 11, 1740. [Google Scholar] [CrossRef]
- Tepe, B.; Sokmen, M.; Akpulat, H.A.; Sokmen, A. In vitro antioxidant activities of the methanol extracts of four Helichrysum species from Turkey. Food Chem. 2005, 90, 685–689. [Google Scholar] [CrossRef]
- Tan, L.T.; Lee, L.H.; Yin, W.F.; Chan, C.K.; Abdul Kadir, H.; Chan, K.G.; Goh, B.H. Traditional uses, phytochemistry, and bioactivities of Cananga odorata (Ylang-Ylang). Evidence-Based Complemen. Alter. Med. 2015, 2015, 896314. [Google Scholar] [CrossRef]
- Afify, A.E.-M.M.R.; El-Beltagi, H.S.; Aly, A.A.; El-Ansary, A.E. Antioxidant enzyme activities and lipid peroxidation as biomarker for potato tuber stored by two essential oils from Caraway and Clove and its main component carvone and eugenol. Asian Pac. J. Trop. Biomed. 2012, 2, S772–S780. [Google Scholar] [CrossRef]
- Ramadan, K.M.A.; El-Beltagi, H.S.; Shanab, S.M.M.; El-fayoumy, E.A.; Shalaby, E.A.; Bendary, E.S.A. Potential antioxidant and anticancer activities of secondary metabolites of Nostoc linckia cultivated under Zn and Cu stress conditions. Processes 2021, 9, 1972. [Google Scholar] [CrossRef]
- Miller, G.L. Use of dinitrosalicylic acid reagent for the determination of reducing sugar. Anal. Chem. 1959, 31, 426–428. [Google Scholar] [CrossRef]
- Halder, S.K.; Maity, C.; Jana, A.; Pati, B.R.; Mondal, K.C. Chitinolytic enzymes from the newly isolated Aeromonas hydrophila SBK1: Study of the mosquitocidal activity. BioControl 2012, 57, 441–449. [Google Scholar] [CrossRef]
- Halder, S.K.; Maity, C.; Jana, A.; Das, A.; Paul, T.; Mohapatra, P.K.; Pati, B.R.; Mondal, K.C. Proficient biodegradation of shrimp shell waste by Aeromonas hydrophila SBK1 for the concomitant production of antifungal chitinase and antioxidant chitosaccharides. Int. Biodeter. Biodegrad. 2013, 79, 88–97. [Google Scholar] [CrossRef]
- Lowry, O.H.; Rosebrough, N.J.; Farr, A.L.; Randall, R.J. Protein measurement with the Fohn phenol reagent. J. Biol. Chem. 1951, 193, 265–275. [Google Scholar] [CrossRef]
- Moore, S.; Spackman, D.H.; Stein, W.H. Chromatography of amino acids on sulfonated polystyrene resins. An improved system. Anal. Chem. 1958, 30, 1185–1190. [Google Scholar] [CrossRef]
- Park, H.R.; Park, E.; Rim, A.R.; Jeon, K.I.; Huang, J.H.; Lee, S.C. Antioxidant activity of extracts from Acanthopanax senticosus. Afr. J. Biotechnol. 2006, 5, 2388–2396. [Google Scholar]
- Re, R.; Pellegrini, N.; Proteggente, A.; Pannala, A.; Yang, M.; Riceevans, C. Antioxidant activity applying an improved ABTS radical cation decolorization assay. Free Radic. Biol. Med. 1999, 26, 1231–1237. [Google Scholar] [CrossRef]
- Espinel-Ingroff, A.; Arthington-Skaggs, B.; Iqbal, N.; Ellis, D.; Pfaller, M.A.; Messer, S.; Rinaldi, M.; Fothergill, A.; Gibbs, D.L.; Wang, A. Multicenter evaluation of a new disk agar diffusion method for susceptibility testing of filamentous fungi with voriconazole, posaconazole, itraconazole, amphotericin B., and caspofungin. J. Clin. Microbiol. 2007, 45, 1811–1820. [Google Scholar] [CrossRef]
- Espinel-Ingroff, A.; Canton, E.; Fothergill, A.; Ghannoum, M.; Johnson, E.; Jones, R.N.; Ostrosky-Zeichner, L.; Schell, W.; Gibbs, D.L.; Wang, A.; et al. Quality control guidelines for amphotericin B, Itraconazole, posaconazole, and voriconazole disk diffusion susceptibility tests with nonsupplemented Mueller-Hinton Agar (CLSI M51-A document) for nondermatophyte Filamentous Fungi. J. Clin. Microbiol. 2011, 49, 2568–2571. [Google Scholar] [CrossRef]
- Mosmann, T. Rapid colorimetric assay for cellular growth and survival: Application to proliferation and cytotoxicity assays. J. Immunol. Meth. 1983, 65, 55–63. [Google Scholar] [CrossRef]
- Wilson, A.P. Cytotoxicity and viability assays. In JRW Masters, Animal Cell Culture, 3rd ed.; Oxford University Press: Oxford, UK, 2000; pp. 175–219. [Google Scholar]
- Karthik, N.; Akanksha, K.; Binod, P.; Pandey, A. Production, purification and properties of fungal chitinases—A review. Indian J. Exp. Biol. 2014, 52, 1025–1035. [Google Scholar]
- Homthong, M.; Kubera, A.; Srihuttagum, M.; Hongtrakul, V. Isolation and characterization of chitinase from soil fungi, Paecilomyces sp. Agri. Natural Reso. 2016, 50, 232–242. [Google Scholar] [CrossRef][Green Version]
- Duo-Chuan, L.I.; Chen, S.; Jing, L.U. Purification and partial characterization of two chitinases from the mycoparasitic fungus Talaromyces flavus. Mycopathol 2005, 159, 223–239. [Google Scholar] [CrossRef]
- Halder, S.K.; Jana, A.; Paul, T.; Das, A.; Ghosh, K.; Pati, B.R.; Mondal, K.C. Purification and biochemical characterization of chitinase of Aeromonas hydrophila SBK1 biosynthesized using crustacean shell. Biocatal. Agri. Biotechnol. 2016, 5, 211–218. [Google Scholar] [CrossRef]
- Kovacs, K.; Szakacs, G.; Pusztahelyi, T.; Pandey, A. Production of chitinolytic enzymes with Trichoderma longibrachiatum IMI 92027 in solid substrate fermentation. Appl. Biochem. Biotechnol. 2004, 11, 189–204. [Google Scholar] [CrossRef]
- Farag, M.A.; Al-Nusarie, S.T. Production, optimization, characterization and antifungal activity of chitinase produced by Aspergillus terreus. Afr. J. Biotechnol. 2014, 13, 1567–1578. [Google Scholar] [CrossRef]
- Shalaby, H.M.; Abo-Sdera, S.A.; Easa, S.M.; Ismail, A.M. Biosynthesis of biologically active chitinase utilizing some Egyptian chitinaceous wastes and the properties of the synthesized enzyme. Egypt Pharm. J. 2019, 18, 320–331. [Google Scholar] [CrossRef]
- Hao, Z.; Cai, Y.; Liao, X.; Zhang, X.; Fang, Z.; Zhang, D. Optimization of nutrition factors on chitinase production from a newly isolated Chitiolytic bacter meiyuanensis SYBC-H1. Braz. J. Microbiol. 2012, 43, 177–186. [Google Scholar] [CrossRef]
- Shivalee, A.; Lingappa, K.; Mahesh, D. Influence of bioprocess variables on the production of extracellular chitinase under submerged fermentation by Streptomyces pratensis strain KLSL55. J. Genet. Eng. Biotechnol. 2018, 16, 421–426. [Google Scholar] [CrossRef]
- Göksungur, M.Y. Optimization of the production of chitosan from beet molasses by response surface methodology. J. Chem. Technol. Biotechnol. 2004, 79, 974–981. [Google Scholar] [CrossRef]
- Flores-Albino, B.; Arias, L.; Gómez, J.; Castillo, A.; Gimeno, M.; Shirai, K. Chitin and L(+)-lactic acid production from crab (Callinectes bellicosus) wastes by fermentation of Lactobacillus sp. B2 using sugar cane molasses as carbon source. Bioprocess Biosyst. Eng. 2012, 35, 1193–1200. [Google Scholar] [CrossRef]
- Sudhakar, P.; Nagarajan, P. Production of chitinase by solid state fermentation from rice bran. Int. J. Environ. Sci. Dev. 2010, 1, 435–441. [Google Scholar] [CrossRef]
- Nagpure, A.; Gupta, R.K. Purification and characterization of an extracellular chitinase from antagonistic Streptomyces violaceusniger. J. Basic Microbiol. 2012, 52, 1–11. [Google Scholar] [CrossRef]
- Saraswathi, M.; Ravuri, J.M. Production and purification of chitinase by Trichoderma harzianum for control of Sclerotium rolfsii. Int. J. Appl. Nat. Sci. IJANS 2013, 2, 65–72. [Google Scholar]
- Farag, A.M.; Abd-Elnabey, H.M.; Ibrahim, H.A.; El-Shenawy, M. Purification, characterization and antimicrobial activity of chitinase from marine-derived Aspergillus terreus. Egypt J. Aquatic. Res. 2016, 42, 185–192. [Google Scholar] [CrossRef]
- Xia, W.; Liu, P.; Zhang, J.; Chen, J. Biological activities of chitosan and chitooligosaccharides. Food Hydrocoll. 2011, 25, 170–179. [Google Scholar] [CrossRef]
- Jana, A.; Maity, C.; Halder, S.K.; Das, A.; Pati, B.R.; Mondal, K.C.; Das Mohapatra, P.K. Structural characterization of thermostable, solvent tolerant, cytosafe tannase from Bacillus subtilis PAB2. Biochem. Eng. J. 2013, 77, 161–170. [Google Scholar] [CrossRef]
- Prasad, M.; Palanivelu, P. Overexpression of a chitinase gene from the thermophilic fungus, Thermomyces lanuginosus in Saccharomyces cerevisiae and characterization of the recombinant chitinase. J. Microb. Biochem. Technol. 2012, 4, 86–91. [Google Scholar] [CrossRef]
- Ghonaim, M.M.; Mohamed, H.I.; Omran, A.A.A. Evaluation of wheat salt stress tolerance using physiological parameters and retrotransposon-based markers. Genet Resour. Crop Evol. 2021, 68, 227–242. [Google Scholar] [CrossRef]
- Afify, A.M.R.; Shalaby, E.A.; El-Beltagi, H.S. Antioxidant activity of aqueous extracts of different caffeine products. Not. Bot. Hort. Agrobot. Cluj-Napoca 2011, 39, 117–123. [Google Scholar] [CrossRef][Green Version]
- Fadhil, L.; Kadim, A.; Mahdi, A. Production of chitinase by Serratia marcescens from soil and its antifungal activity. J. Nat. Sci. Res. 2014, 4, 80–86. [Google Scholar]
- Lin, Y.C.; Xi, Y.; Xie, H.; Liu, B.; Zhang, M.; Peng, H. Purification, characterization and antifungal activity of chitinase from Trichoderma viride n9. Acta Phytophyl. Sinica 2009, 36, 295–300. [Google Scholar]
- Rafael, O.H.; Fernándo, Z.G.; Abraham, P.T.; Alberto, V.L.; Guadalupe, G.S.; Pablo, P.J. Production of chitosan-oligosaccharides by the chitin-hydrolytic system of Trichoderma harzianum and their antimicrobial and anticancer effects. Carbohy. Res. 2019, 486, 107836. [Google Scholar] [CrossRef]
- Olicón-Hernández, D.R.; Hernández-Lauzardo, A.N.; Pardo, J.P.; Peña, A.; Velázquez-del Valle, M.G.; Guerra-Sánchez, G. Influence of chitosan and its derivatives on cell development and physiology of Ustilago maydis. Int. J. Biol. Macromol. 2015, 79, 654–660. [Google Scholar] [CrossRef]
- Abu-Tahon, M.A.; Isaac, G.S. Anticancer and antifungal efficiencies of purified chitinase produced from Trichoderma viride under submerged fermentation. J. Gene. Appl. Microbiol. 2020, 66, 32–40. [Google Scholar] [CrossRef]
- Liaqat, F.; Eltem, R. Chitooligosaccharides and their biological activities: A comprehensive review. Carbohydr. Polym. 2018, 184, 243–259. [Google Scholar] [CrossRef]

| Substrate | Weight of Substrate: Volume of Medium (w/v) * | |||||||||
|---|---|---|---|---|---|---|---|---|---|---|
| 1:1 | 1:2 | 1:3 | 1:4 | 1:5 | ||||||
| ** MC (%) | Chitinase Activity (U/g Substrate) | ** MC (%) | Chitinase Activity (U/g Substrate) | ** MC (%) | Chitinase Activity (U/g Substrate) | ** MC (%) | Chitinase Activity (U/g Substrate) | ** MC (%) | Chitinase Activity (U/g Substrate) | |
| Chitin (Sigma) | 55.45 | 1.7 ± 0.1a | 70 | 1.72 ± 0.2b | 77.14 | 2.35 ± 0.2a | 81.54 | 2.07 ± 0.1a | 84.52 | 1.51 ± 0.1a |
| Crab shell chitin | 56.36 | 1.3 ± 0.1b | 69.37 | 2.98 ± 0.2a | 76.66 | 1.56 ± 0.2b | 81.15 | 1.24 ± 0.1c | 84.19 | 1.02 ± 0.1b |
| Shrimp shell chitin | 56.36 | 0.17 ± 0.01c | 70.0 | 0.32 ± 0.05c | 77.14 | 0.46 ± 0.01c | 81.54 | 1.40 ± 0.1b | 84.52 | 0.92 ± 0.05b |
| Crayfish shell chitin | 55.45 | 0.04 ± 0.01d | 69.37 | 0.13 ± 0.02d | 76.66 | 0.26 ± 0.01d | 81.15 | 0.39 ± 0.05d | 84.19 | 0.31 ± 0.02c |
| Purification Step | Protein (mg/mL) | Activity (U/mL) | Specific Activity (U/mg Protein) | Recovery % | Purification Fold |
|---|---|---|---|---|---|
| Cell Free Filtrate (CFF) | 4.14 ± 0.2a | 17.56 ± 0.6a | 4.23 ± 0.1d | 100 | 1.0 |
| Cell Free Dialysate (CFD) | 3.66 ± 0.3b | 16.23 ± 0.5b | 4.40 ± 0.1d | 92.4 | 1.04 |
| Ammonium sulfate (60%) | 1.56 ± 0.1c | 12.86 ± 0.6c | 8.21 ± 0.2c | 73.3 | 1.93 |
| Sephadex–G100 (S-G100) | 1.12 ± 0.1d | 9.66 ± 0.3d | 8.63 ± 0.2b | 65.4 | 2.89 |
| DEAE cellulose | 1.00 ± 0.1d | 9.32 ± 0.3d | 9.32 ± 0.3a | 60.8 | 7.22 |
| Metal Ions | Conc. (mM) | Relative Enzyme Activity (%) |
|---|---|---|
| Control | 0 | 100 ± 5.0 |
| Na+ | 5 | 120 ± 7.0 |
| 10 | 110 ± 8.0 | |
| Mg2+ | 5 | 110 ± 6.0 |
| 10 | 80.5 ± 5.0 | |
| Mn2+ | 5 | 115 ± 9.0 |
| 10 | 105 ± 9.0 | |
| Hg2+ | 5 | 70 ± 8.0 |
| 10 | 45.5 ± 4.0 | |
| Zn2+ | 5 | 100 ± 5.0 |
| 10 | 100 ± 5.0 | |
| Ca2+ | 5 | 150 ± 10.0 |
| 10 | 120 ± 10.0 | |
| Co2+ | 5 | 100 ± 6.0 |
| 10 | 100 ± 5.0 | |
| Cu2+ | 5 | 130 ± 8.0 |
| 10 | 82.9 ± 6.0 | |
| Ag2+ | 5 | 60 ± 4.0 |
| 10 | 40 ± 4.0 | |
| Li+ | 5 | 60 ± 3.0 |
| 10 | 50 ± 4.0 | |
| EDTA | 5 | 92 ± 5.0 |
| 10 | 90 ± 8.0 | |
| PMSF | 5 | 93 ± 6.0 |
| 10 | 91 ± 5.0 | |
| SDS | 5 | 95 ± 7.0 |
| 10 | 92 ± 9.0 | |
| Tween-80 | 5 | 95 ± 7.0 |
| 10 | 93 ± 8.0 |
| Treatment | Concentration (µg/mL) | % Inhibition of DPPH | IC50 (μg/mL) | % Inhibition of ABTS | IC50 (μg/mL) |
|---|---|---|---|---|---|
| Purified enzymes | 100 | 48.73 ± 1.0 | 199 | 8.87 ± 0.5 | 306 |
| 200 | 50.55 ± 2.0 | 29.77 ± 1.0 | |||
| 300 | 55.07 ± 2.2 | 57.46 ± 1.5 | |||
| 400 | 57.76 ± 1.9 | 63.73 ± 1.8 | |||
| Ascorbic acid | 5 | 12.5 ± 1.0 | 30.3 | 25.2 ± 1.0 | 20.0 |
| 10 | 28.9 ± 1.5 | 38.4 ± 1.2 | |||
| 20 | 40.1 ± 1.6 | 48.5 ± 1.6 | |||
| 40 | 60.2 ± 2.3 | 80.2 ± 1.9 | |||
| Butylated hydroxytoluene (BHT) | 5 | 22.1 ± 0.9 | 19.0 | 35.3 ± 1.2 | 11.8 |
| 10 | 35.3 ± 1.3 | 50.2 ± 1.4 | |||
| 20 | 60.2 ± 1.8 | 65.9 ± 1.6 | |||
| 40 | 80.5 ± 2.5 | 90.4 ± 2.2 |
| Pathogenic Microorganism | Inhibitions Zones (mm) | Con. |
|---|---|---|
| Gram-positive bacteria | ||
| Bacillus subtilis (ATCC 6633) | 24 ± 1.3 | 17 |
| Staphylococcus aureus v (ATCC 6538) | 20 ± 1.0 | 19 |
| Gram-negative bacteria | ||
| Escherichia coli (ATCC 8739) | 29 ± 1.2 | 25 |
| Pseudomonas aeruginosa (ATCC 90274) | 38 ± 1.5 | 22 |
| Fungi | ||
| Candida albicans (ATCC 10221) | 25 ± 1.2 | 21 |
| Aspergillus niger | 26 ± 1.4 | 16 |
| Cell Line | Conc. of Purified Chitinase µg/mL | Mean O.D | ST.E | Viability % | Toxicity % | IC50 µg/mL |
|---|---|---|---|---|---|---|
| Mcf7 | Control | 0.553 | 0.010 | 100 | 0 | |
| 1000 | 0.0167 | 0.001 | 3.01 | 97.0 | 101.81 | |
| 500 | 0.0177 | 0.003 | 3.20 | 96.8 | ||
| 250 | 0.068 | 0.008 | 12.36 | 87.6 | ||
| 125 | 0.175 | 0.010 | 31.65 | 68.4 | ||
| 62.5 | 0.459 | 0.012 | 82.94 | 17.1 | ||
| 31.25 | 0.547 | 0.006 | 98.92 | 1.08 | ||
| HCT116 | Control | 0.374 | 0.008 | 100 | 0 | |
| 1000 | 0.044 | 0.004 | 11.76 | 88.2 | 411.45 | |
| 500 | 0.125 | 0.006 | 33.51 | 66.5 | ||
| 250 | 0.304 | 0.008 | 81.28 | 18.7 | ||
| 125 | 0.366 | 0.004 | 97.95 | 2.05 | ||
| 62.5 | 0.372 | 0.005 | 99.55 | 0.45 | ||
| 31.25 | 0.374 | 0.0046 | 99.91 | 0.09 | ||
| HepG2 | Control | 0.599 | 0.0089 | 100 | 0 | |
| 1000 | 0.017 | 0.0008 | 2.892 | 97.1 | 118.74 | |
| 500 | 0.02 | 0.001 | 3.34 | 96.7 | ||
| 250 | 0.09 | 0.005 | 15.75 | 84.3 | ||
| 125 | 0.256 | 0.004 | 42.79 | 57.2 | ||
| 62.5 | 0.573 | 0.007 | 95.66 | 4.3 | ||
| 31.25 | 0.598 | 0.007 | 99.839 | 0.167 |
Publisher’s Note: MDPI stays neutral with regard to jurisdictional claims in published maps and institutional affiliations. |
© 2022 by the authors. Licensee MDPI, Basel, Switzerland. This article is an open access article distributed under the terms and conditions of the Creative Commons Attribution (CC BY) license (https://creativecommons.org/licenses/by/4.0/).
Share and Cite
El-Beltagi, H.S.; El-Mahdy, O.M.; Mohamed, H.I.; El-Ansary, A.E. Antioxidants, Antimicrobial, and Anticancer Activities of Purified Chitinase of Talaromyces funiculosus Strain CBS 129594 Biosynthesized Using Crustacean Bio-Wastes. Agronomy 2022, 12, 2818. https://doi.org/10.3390/agronomy12112818
El-Beltagi HS, El-Mahdy OM, Mohamed HI, El-Ansary AE. Antioxidants, Antimicrobial, and Anticancer Activities of Purified Chitinase of Talaromyces funiculosus Strain CBS 129594 Biosynthesized Using Crustacean Bio-Wastes. Agronomy. 2022; 12(11):2818. https://doi.org/10.3390/agronomy12112818
Chicago/Turabian StyleEl-Beltagi, Hossam S., Omima M. El-Mahdy, Heba I. Mohamed, and Abeer E. El-Ansary. 2022. "Antioxidants, Antimicrobial, and Anticancer Activities of Purified Chitinase of Talaromyces funiculosus Strain CBS 129594 Biosynthesized Using Crustacean Bio-Wastes" Agronomy 12, no. 11: 2818. https://doi.org/10.3390/agronomy12112818
APA StyleEl-Beltagi, H. S., El-Mahdy, O. M., Mohamed, H. I., & El-Ansary, A. E. (2022). Antioxidants, Antimicrobial, and Anticancer Activities of Purified Chitinase of Talaromyces funiculosus Strain CBS 129594 Biosynthesized Using Crustacean Bio-Wastes. Agronomy, 12(11), 2818. https://doi.org/10.3390/agronomy12112818

